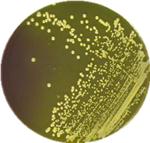
杀灭金黄葡萄球菌的精油 (抑制金黄色葡萄球菌的精油)

=广藿香 Patchouli=

广藿香
Patchouli
Pogostemon cablin
唇形科(Labiatae)
刺蕊草属(Pogostemon)
多年生芳香草本或半灌木
金黄色葡萄球菌---

金黄色葡萄球菌是人体皮肤和鼻腔的常见定植菌,同时也是引起临床感染的常见致病菌,既可引起局部化脓性感染,如疖、痈、毛囊炎、甲沟炎和外科切口、创伤等局部化脓性感染,也可引起肺炎、骨髓炎、脑膜炎、化脓性关节炎、心内膜炎及脓毒症、败血症等全身性感染。随着抗生素广泛应用于临床,金黄色葡萄球菌耐药菌株不断出现,并且呈现多重耐药性。

感染 恢复
金黄色葡萄球菌的耐药性---
金黄色葡萄球菌耐药性的获得,一方面可以通过细菌自身表型的改变、代谢通路的调整等,对抗生素产生适应性耐药(adaptive resistance),如金黄色葡萄球菌生物被膜的产生、形成小菌落、细胞壁增厚以及持留菌的产生都可以对抗生素产生较高的耐药性。
另一方面,金黄色葡萄球菌可以通过水平转移等方式获得耐药基因,如金黄色葡萄球菌获得产生β-内酰胺酶基因后即可呈现对β-内酰胺类抗生素的耐药性。
自1961年发现第一株耐甲氧西林金黄色葡萄球菌(methicillin-resistant Staphylococcusaureus, MRSA)以来,MRSA在临床的感染率和分离率不断增加,并且在世界范围内广泛传播,成为全球院内感染的首要病原菌。
广藿香精油的抑菌活性及其作用机制---
以金黄色葡萄球菌为供试菌,探讨广藿香精油的抑菌活性及其作用机制。
通过测定广藿香精油对甲氧西林敏感金黄色葡萄球菌(MSSA)和耐甲氧西林金黄色葡萄球菌(MRSA)的抑菌活性,对金黄色葡萄球菌ATCC 25923的抑菌曲线、超微结构、细胞壁透性和肽聚糖的量、膜蛋白构象和离子渗漏的影响,来阐述广藿香精油的抑菌活性及作用机制。

广藿香精油对受试菌的MICs为0.51 mg/mL能明显延长受试菌生长的延迟期,抑制细菌的生长;破坏细胞的结构完整性,损伤胞膜;影响受试菌细胞壁透性,膜蛋白的构象;导致胞体K+、Mg2+的渗出;但在检测时间内对受试菌细胞壁肽聚糖的量无明显影响。
结 论---
广藿香精油对MSSA和MRSA有显著抑制作用,其抑菌机制与破坏细胞的结构完整性和损伤胞膜,影响细胞壁和细胞膜的通透性,改变膜蛋白构象有关。
参考文献---
1. Yuan WC, Rao XC. Study on the adaptive resistance of Staphylococcus aureus and the regulation mechanism of MRSA resistance. 2013
2. Wan F, Peng C, CAO XY, Xiong L, Wei XL, Zhou YX, et al. Patchouli essential oil on antibacterial activity and mechanism of Staphylococcus aureus. 2012
3. Betty C.-R. Zhu,Gregg Henderson,Ying Yu,Roger A. Laine.Toxicity and Repellency of Patchouli Oil and Patchouli Alcohol against Formosan Subterranean Termites Coptotermes formosanus Shiraki. Journal of Agriculture . 2003
IAS年会宣讲主题
